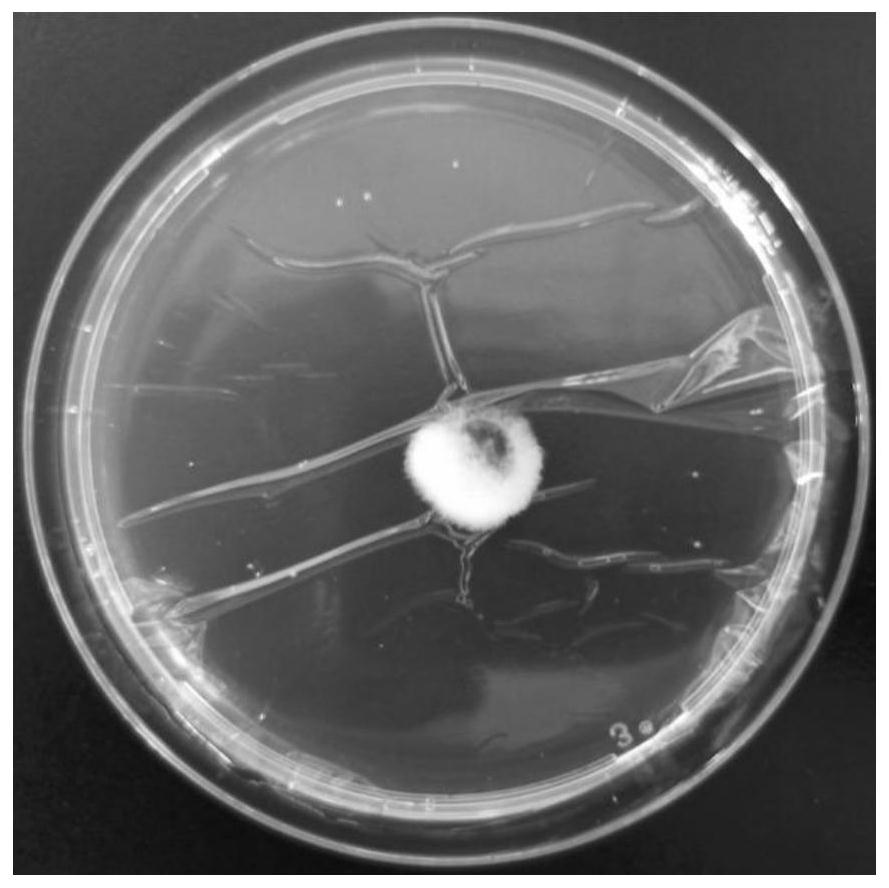
cn112375689a_菌丝培养方法及利用其制备和再生原生质体的方法在审

细菌菌丝

菌丝体
图片尺寸525x350菌丝
图片尺寸600x400检验白带菌丝
图片尺寸1080x1080
菌丝体图片
图片尺寸527x350孢子菌丝
图片尺寸1080x1439
灵芝菌丝体是什么有什么特点
图片尺寸650x420
西梅 菌丝
图片尺寸2250x4000
明润农业孝感羊肚菌种植基地菌丝长势喜人
图片尺寸2000x3554
高校微生物实验切片 雨林玻片 教学标本 曲霉示菌丝和孢子装片
图片尺寸750x750次生菌丝
图片尺寸1280x1034
菌丝图片
图片尺寸451x300
菌丝体
图片尺寸781x448
菌丝是这样子的
图片尺寸3000x2000菌丝
图片尺寸577x577z型菌丝
图片尺寸2560x1920
喜欢
图片尺寸620x547
和大型真菌;霉菌,意即"发霉的真菌",它们往往能形成分枝繁茂的菌丝体
图片尺寸2592x1944
显微镜下霉菌的菌丝体,就是这个菌折磨我千百遍…… 显微镜下霉菌的
图片尺寸1080x810
cn112375689a_菌丝培养方法及利用其制备和再生原生质体的方法在审
图片尺寸889x888
体微生物真菌菌丝体丝状体增加40倍的显微镜观察照片
图片尺寸288x300